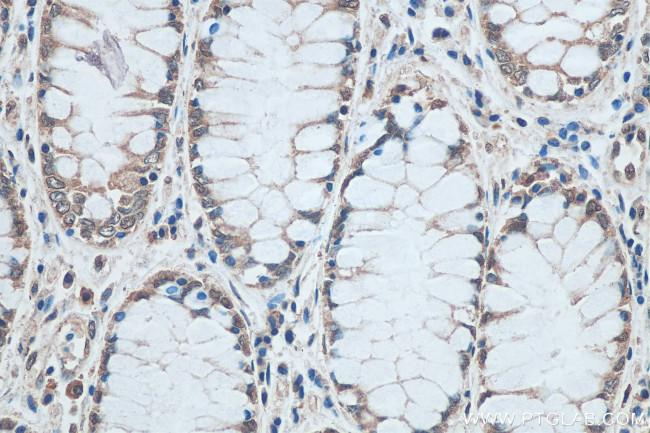
SNRPN Antibody in Immunohistochemistry (Paraffin) (IHC (P))

Search
Proteintech
SNRPN Monoclonal Antibody (1H2F4)
{{$productOrderCtrl.translations['antibody.pdp.commerceCard.promotion.promotions']}}
{{$productOrderCtrl.translations['antibody.pdp.commerceCard.promotion.viewpromo']}}
{{$productOrderCtrl.translations['antibody.pdp.commerceCard.promotion.promocode']}}: {{promo.promoCode}} {{promo.promoTitle}} {{promo.promoDescription}}. {{$productOrderCtrl.translations['antibody.pdp.commerceCard.promotion.learnmore']}}
产品信息
67280-1-IG
种属反应
宿主/亚型
分类
类型
克隆号
抗原
偶联物
形式
浓度
规格
纯化类型
保存液
内含物
保存条件
运输条件
产品详细信息
Aliquoting is unnecessary for -20°C storage.
靶标信息
The protein encoded by this gene is one polypeptide of a small nuclear ribonucleoprotein complex and belongs to the snRNP SMB/SMN family. The protein plays a role in pre-mRNA processing, possibly tissue-specific alternative splicing events. Although individual snRNPs are believed to recognize specific nucleic acid sequences through RNA-RNA base pairing, the specific role of this family member is unknown. The protein arises from a bicistronic transcript that also encodes a protein identified as the SNRPN upstream reading frame (SNURF). Multiple transcription initiation sites have been identified and extensive alternative splicing occurs in the 5' untranslated region. Additional splice variants have been described but sequences for the complete transcripts have not been determined. The 5' UTR of this gene has been identified as an imprinting center. Alternative splicing or deletion caused by a translocation event in this paternally-expressed region is responsible for Angelman syndrome or Prader-Willi syndrome due to parental imprint switch failure.
仅用于科研。不用于诊断过程。未经明确授权不得转售。
篇参考文献 (0)
生物信息学
蛋白别名: DKFZp686C0927; DKFZp686M12165; DKFZp761I1912; DKFZp762N022; FE294 gene for snRNP-associated polypeptide N; FE294 psi pseudogene; FLJ33569; FLJ36996; FLJ39265; MGC29886; Sm protein D; SM protein N; Sm-D; Sm-N; small nuclear ribonucleoparticle-associated protein (snRNP) mRNA clone Sm51; small nuclear ribonucleoparticle-associated protein (snRNP) mRNA, clone Sm51; small nuclear ribonucleoprotein; small nuclear ribonucleoprotein N; Small nuclear ribonucleoprotein-associated protein N; smN; snRNP-N; SNRPN; tissue-specific splicing protein; Tissue-specific-splicing protein; unnamed protein product
基因别名: 2410045I01Rik; FE 294; FE 294 psi; FE294; FE294 psi; HCERN3; Peg4; PWCR; Pwcr1; RT-LI; SM-D; sm-N; SMN; SNRNP-N; SNRPN; SNURF-SNRPN
UniProt ID: (Human) P63162, (Rat) P63164, (Mouse) P63163
Entrez Gene ID: (Human) 6638, (Rat) 81781, (Mouse) 20646